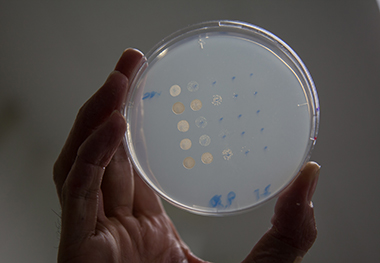
05_img_2331

遊びから自然の法則を学ぶ
小学生のころの記憶にあるのは、上の弟を連れてよく西宮から神戸の三宮まで父を迎えに行ったこと。レンガ造りの国鉄三ノ宮駅に「特急かもめ」が入ってくるのを待ちわびました。父は、戦時中に戦闘機「紫電改」を製造していた川西航空機の社員でした。戦後は新明和工業となり、航空産業からオートバイや油圧機器の製造に転換したので、営業のために九州と本社のある関西を始終行き来していたのです。
赤ん坊のころ赤痢にかかって生死をさまよったことがあり、「この子は大事に育てなくては」と母は考えたようです。積み木や本を与えられ、家の中で過ごすことが多かったですね。おかげで運動は大の苦手で、2歳下の弟の方が先に自転車に乗れるようになったくらいです。いっぽう手先は器用でした。小学校の高学年のころには一通りの電気工作ができて、鉄の枠と回転子にコイルを巻き付けて電池につなぎ、モーターが回り出すのをわくわくしながら眺めたものです。自作のプロペラ飛行機もよく飛びました。竹ひごをロウソクの火であぶって曲げ、飛行機の骨組みを作るのです。学校の理科の問題は、僕にとっては非常に簡単でしたね。「回路をどのようにつなぐと豆電球が点くか」、「どこにおもりをぶら下げれば天秤が釣り合うか」など、教わらなくてもすぐ分かりました。遊びの中で、自然の法則を利用する術を身に付けていたのでしょう。
赤ん坊のころ。兵庫県の加古川市に生まれた。
幼稚園の学芸会。先生の合図を見よう見まねで指揮棒を振った。クラシック音楽は今でも大好きだ。(本人:指揮者)
小学生の頃の家族写真。多忙だった父(後列右)と囲碁の対局をしたのが良い思い出だ。(本人:前列左から2番目)
両親に頼みこんでクリスマスに買ってもらった、念願のカメラを手に。
分子と分子が出会う不思議
中学1年生のとき父の転勤で東京へ引っ越すことになり、半年在籍した灘中学校から東京の開成中学校に編入学しました。このころは真空管ラジオの製作やアマチュア無線に凝っていて、学校帰りに秋葉原へ寄っては電気部品を買い集め、アルミ板の上に一から回路を設計したものです。学校では物理や数学が得意でした。問いに対して、論理的に明確な答えが出てくる学科が好きだったのです。いっぽう、地理や世界史などの暗記科目の成績はギリギリでした。生物も暗記科目として習っていれば苦手になっていたでしょうが、開成中学では生物の授業に実験を多く取り入れていたのが幸いでした。サメの解剖実習などのユニークな授業を通して、生物の生きるしくみに興味を持つようになったのです。
親と子が似るのは遺伝子によるものだと教わり、メンデルの遺伝の法則も頭ではすぐ理解できました。しかし遺伝子の実体とは何なのか、世代を越えて情報を伝える物質が、生物の中に存在するのだろうか。考えれば考えるほど謎が深まる一方でした。そのころ世界では、遺伝子の正体がDNA(デオキシリボ核酸)という物質であることがとっくに明らかになっていたのですが、日本の教育にはその情報が入っていなかったのです。
もう一つ印象に残ったのが減数分裂でした。有性生殖において、両親からのゲノムを半分ずつ引き継ぐために無くてはならないステップです。高校の授業で誰もが教わるものですが、僕には不思議でなりませんでした。細胞内にたった一つずつしかない相同な染色体どうしが確実に出会うでしょう。物理学では説明しようのない現象です。例えば熱力学などでは、無数の分子のランダムな運動を統計学的な全体像として捉えると、物体の熱や圧力といった一つの物性に収まるのだという見方をします。この観点からすると、細胞内に一つしかないものが適切なタイミングで動き、確実に出会うなんて非常におかしなことですよね。この謎は、減数分裂を追いかけて30年以上経った今もまだ完全には解けていません。
中学生の頃。クラシック音楽が聞きたくて、東京に引っ越してからはテレビの公開収録に通った。中村紘子さんによる「華麗なる大円舞曲」の演奏は、男子中学生には目にも眩しかった。
開成高校の運動会で「借り人競争」に出たときの一枚。真ん中で舌を出しているのは古文の名物教師・板谷先生。授業も人柄もユニークな先生ばかりで、ずいぶん影響を受けた。
友達と長野県の南相木村に滞在。受験勉強に専念するのが目的だったが、村の盆踊りに出たりと随分遊んだ記憶もある。(本人:後列右から2番目)
新しい生物学が始まる
物理に興味があったことと、いざという時に就職しやすい工学系に進学できることもあり、東京大学の理科一類に進みました。大学で、遺伝子の実体がDNAであることが既に解明されたと知ったときは正直がっかりしましたね。しかしアメリカでは、この発見に端を発する新しい学問が生まれたとも聞きました。DNAやタンパク質など、生きものを構成する分子のはたらきから生命現象を説明する「分子生物学」の幕開けです。我が国でも、これまでの生物学に飽き足らない人が様々な分野から集結し、この新しい生物学を始めようとしていました。日本での創始者・渡辺格先生を中心に、物理学者の大沢文夫先生や、海外で最先端の技術を学んできた小関治男先生、大澤省三先生など気鋭の研究者たちです。観察や記載研究が中心だったこれまでの生物学とは異なり、生物の生きるしくみを論理的に説明する学問だという点に惹かれました。理科一類からの進学先の中で唯一それを学べる、理学部生物化学科を専攻することを決めたのです。
ここから本格的に研究の道を歩もうと決心するまでには、いろんな曲折がありました。専攻を決めた3年生のころ、東京大学は大学闘争の真っ只中。皆が漠然と、このままの世の中では良くないと感じていた時代です。僕もよく集会に出向いて、大学や社会、そして自分たちのあるべき姿についての議論に明け暮れました。教授達に向かって「あなた方は世の中が何も見えていない。専門馬鹿じゃないですか」などと、随分失礼なことも言いましたね。そんな中、父が病気で亡くなったのです。東大闘争の勢いが最高潮に達する、安田講堂事件安田講堂事件1969年1月、全共闘派学生が東京大学の安田講堂を占拠し、機動隊との間で3日間にわたり攻防が行われた事件。の直前のことでした。長男として家族の生活や自分の将来を考えざるを得ない立場に一転したわけです。
運動から身を引き、家の後始末に追われながらも、常に三つの問題意識が頭にありました。一つは家族と自分の生活をどうするか。二つ目は、自分たちが起こした東大闘争という問題提起にどう責任をとるか。そして最後に、学業として何を研究し、いつまで続けるか。まずは生活を何とかしなくてはなりません。私と下の弟は、自宅に近所の子どもを集めて勉強を教える仕事を始め、大阪大学にいた上の弟は社会体験派でもあったので、中央市場のこんにゃく屋で早朝アルバイトを始めました。すると地道に暮らしていれば母子家庭でも案外何とかなるもので、兄弟三人で頑張るうち、大学院に進んで研究を続けられる見通しが立ってきたのです。一連の転機から悟ったのは、世の中の在り方が見えていなかったのは僕の方だということでした。学生が頭だけでいくら議論しても、最も過激なことを言った人が勝つだけです。自分たちの生活や日常に根差した問題として捉えなければ、人を動かすような意味のある行動には繋がりません。社会の中で「自分が何者であるか」を確立するために、まずは研究を一番大事にしようと決めました。あのころから、自分なりに筋を通してやってきたつもりです。
分子生物学の幕開けを支えたのは、大腸菌とそれに感染するバクテリオファージというウイルスの実験系です。そこで大学院は、大腸菌とファージの分子生物学を進めようとしていた内田久雄先生の研究室を選び、ファージの構造バクテリオファージの構造
バクテリオファージの頭部にはDNAが格納され、尾部には大腸菌に感染するための構造をもつ。
と遺伝子の関係を調べました。T4ファージが大腸菌に感染するときは、まずその足に相当する部分が大腸菌にくっつきます。すると尾部が収縮して針が現れ、注射器のように大腸菌の細胞膜に刺さり、ファージのDNAが細胞内に注入されるのです。細胞よりもはるかに小さく単純な構造で、どうやってそんな器用なことができるのか不思議でしょう。ファージの突然変異体をスクリーニング(選抜)するという方法で調べてみると、感染のステップそれぞれにはたらく遺伝子があることが分かりました。例えば尾部の構造に関わる遺伝子に突然変異があると、温度が上がっただけで勝手に尾部の収縮が起きてしまったり、足の先の構造に関わる遺伝子に変異があると、大腸菌に感染できなくなったりすることが分かったのです。
当時の突然変異体を使った分子遺伝学の仕事はアイデアを競う風潮があり、いかに培地の条件などを工夫して面白い突然変異体を取得するかが試されました。めずらしい昆虫が採れるとマニアの間で自慢できるのと似た感じで、知恵比べのような雰囲気がありましたね。個人のアイデアで仕事をして、分子生物学者の間で筋がいいと認めてもらえるかどうか、という時代でした。
修士1年のころ、内田久雄先生(中央)の研究室メンバーで尾瀬に遊びに行った時の一枚。分子進化学に進んだ矢原一郎さん(右端)、発生の分子生物学に進んだ西郷薫さん(左から3番目)など、卒業後に新しい分野を切り開いた先輩も少なくない。(本人:左端)
本場の分子生物学に驚く
学位を取ってすぐ、リボソーム研究で名高いウィスコンシン大学の野村眞康先生の元へ留学しました。自ら強く希望したわけではありません。内田先生から野村先生がポスドクを探していると聞き、深く考えずに「じゃあ行きましょうか」というような乗りで留学を決めたのです。たった3年半の留学でしたが、先生とはその後30年以上お付き合いが続きました。大切な縁だったと思います。
野村先生の研究室には見たことのない最新の実験機器が並んでいて、アメリカとの国力の差を実感しましたね。1975年のことです。それ以上に驚いたのは、研究室の体制の違いでした。研究室にはテクニシャンが7〜8名もいて、システマティックに実験を分担していたのです。例えば、タンパク質の二次元電気泳動を担当するテクニシャンはそれだけを専門的にやるので、迅速に再現性の高い結果を出すことができました。個人か、せいぜい数名単位で全てを行う日本の研究室しか知らない僕にはとても新鮮な光景でした。分子生物学は良く切れる剃刀ではなく、樹を切り倒す斧で勝負しなければならないと思い知りました。
リボソームは、DNAから写し取られた遺伝子の情報をタンパク質に置き換える細胞小器官です。その正体は、53種類ものタンパク質と3種類のRNAが組み合わさった立体分子です。野村先生は共同研究者のピーター・トラウブ博士や水島昭二先生と、この複雑な分子を試験管内で再構成することに世界で初めて成功し、アセンブリー(組み立て)の道筋を明らかにしていました。試験管で作ったリボソームは、細胞内にある本物のリボソームと同じようにタンパク質の工場としてはたらくのです。この実験系を使ってリボソームの各構成分子の役割を解明する道を開いた先生は、長い間ノーベル賞候補と言われていましたね。
僕が留学したころの先生は、一念発起して新しいテーマを始めていました。試験管内での再現には成功しましたが、生きた細胞内でリボソームがどうやってつくられるのかについては、まだ多くの謎が残っていました。不思議なことに、細胞内にある完成したリボソームの周囲に、その部品となるタンパク質は見当たらないのです。つまり、部品が一切余らないよう厳密な1対1対1で各タンパク質がつくられているわけです。50種類もの分子の部品をどうやって過不足なく作り、正確に組み上げるのか。遺伝子の情報を元にリボソームがつくられる過程を追う事で、先生はこの謎に挑戦していました。
野村先生はリボソーム合成に関わる遺伝子の配置が鍵だと考えていました。一連の遺伝子がゲノムDNA上の近い位置に存在していて、同じ転写単位転写単位オペロンとも。単一のプロモーターから一本のRNAとして転写されるDNA領域。真核生物では通常、転写単位は一つの遺伝子から成るが、原核生物では複数の遺伝子が一つの転写単位を形成する。として一気に転写されれば、その産物であるRNAやタンパク質の量は等しくなるはずだからです。ちょうどDNAの塩基配列を直接調べることができるマクサム・ギルバート法が発明されたころで、先生はさっそく学生をギルバートの所へ派遣して手法を習わせていましたね。発見されたばかりの制限酵素もいち早く取り入れました。僕のいささかの寄与も加えて、たった2〜3年のうちに、予想通りリボソーム合成に関わる一連の遺伝子が、ゲノムDNA上に近接して並んでいることが明らかになったのは圧巻でしたね。しかし全ての遺伝子が一つの転写単位を構成するというような単純な結果ではありませんでした。これらの遺伝子がどのように量的な調和を取っているのかが分かったのは、僕が帰国してからのことでした。実はリボソームの構成分子であるタンパク質のいくつかは、翻訳前の自身のmRNA配列の前方にくっついて、その翻訳を止めることができるのです。これらのタンパク質は、初めのうちは部品としてリボソームに次々と組み込まれていくのですが、リボソームに行き渡って供給が過剰になると、自身のmRNAにくっついて翻訳を止めるリプレッサーになるのです。自律的なフィードバックのしくみが、余分な部品を作ってしまわないための要だったわけです。
研究室は常に活気があり、2週間に一度は誰かが新しい発見をするといった具合でした。新しい手法が生まれ、遺伝子の配列やはたらき方から、生物が生きるのに不可欠なしくみが次々と明らかになった時代でした。野村先生は、例えば遺伝学的実験と生化学的実験のように、少なくとも二方向からの解析で支持されない限り、論文で結論的な記述はしないという原則を貫いておられました。生物学において単線の実験で安易な結論を出すことの危険性をよくご承知だったのだと思います。この教えも僕が野村先生から学んだ大きなことの一つでした。
留学時代、野村先生ご夫妻と一緒に。先生の研究室でアメリカらしい研究の方法を学んだ。(本人:左端)
日本へ一時帰国した際に出会った出身学科の後輩と結婚が決まり、野村研究室に留学していた伊藤菁莪さん(元・協和メディックス社長)が大学の宿舎でお祝いパーティーを開いてくれた。当時ウィスコンシン大学にいた日本の研究者が集まった。
植物ホルモン研究の島本功さん(故人:3列目左から2番目)、DNA修復研究の花岡文雄さん(現・筑波大学教授:階段上、右から2番目)、脂質生化学の西島正弘さん(現・昭和薬科大学長:4列目左端)、微小管研究の栗山了子さん(現・ミネソタ大学教授:3列目右端)らがいる。
(本人:2列目左から3番目、妻:本人右隣、近藤寿人さん:撮影)
分裂酵母との出会い
大学院時代からの知り合いだった柳田充弘さんの助手として採用してもらえることになりました。柳田さんは、京都大学に新設された生物物理学教室の助教授としてスイス留学から帰国していましたが、教授への昇任が決まりそうなのを機に、一緒に何か新しいことを始めようと言ってくれたのです。
大腸菌の研究によって、遺伝子のはたらきを支えるDNAの転写・翻訳などの基本的なしくみは明らかになり、世間の関心はより複雑な生命現象へ向かっていました。僕が次のテーマとして思い描いたのは、高校生のころに興味を持った減数分裂です。真核生物に特有のこの現象を、いよいよ調べられるかもしれない。適当な材料となる真核生物を求めて、日本への帰国前に、米国で微生物を研究している色々な研究室を訪ねて話を聞きました。そして、大腸菌とほぼ同じように扱える酵母がいいなと思ったのです。
当時、世界の酵母研究の中心は、ビールやパン作りに使われる出芽酵母でした。親細胞から芽が出るように娘細胞が分裂するのでこの名前があります。当時は酵母のことを何も知りませんでしたから、帰国後すぐにいくつもの酵母研究グループに話を聞きに行き、分子生物学を組み込んでいけないかを考えていきました。日本女子大の大隅正子先生や慶應大の深沢俊夫先生に話を聞きに行ったり、アサヒビールの工場で開かれた研究集会に足を運んだりと、色々な人に教えを請いました。京都に落ち着いてからは、阪大の発酵工学の大嶋泰治先生の酵母実験トレーニングコースに出て人脈も広がりました。しかしそのころ、アメリカではジェリー・フィンクらが既に出芽酵母の形質転換系を開発していました。彼らのやり方は、面白いことが見つかったら徹底的に人とお金を集中させるというアメリカ流で、同じ材料ではとても太刀打ちできません。どうしようかと迷っていた時、ヨーロッパを中心に研究されている「分裂酵母」という酵母があることを知ったのです。
分裂酵母について調べてみると、出芽酵母と違って染色体地図すら十分に分かっていないようです。少し不安ではありましたが、まず分裂酵母の遺伝学の創始者であるベルン大学のロイポルド教授に手紙を書きました。実験用の株を分けて欲しいという依頼だったのですが、先生が思いのほか親切に対応してくれたのです。その数年後には、先生の60歳の誕生日に世界中の分裂酵母研究者が集まるというので声をかけてもらうことができました。行ってみると、コミュニティ全体が小さく、競争でギスギスもしていない。こんなに牧歌的雰囲気の研究社会がまだ残っていたのかと驚きました。しかもその中には、後にノーベル賞を獲ったポール・ナースのように、やる気があってシャープな若手研究者もいる。まだまだ発展が望める分野であり、こういう雰囲気ならこれからもやっていけそうだと、分裂酵母を選択したことに改めて自信がもてました。
阪大の大島泰治さん(前列右端)が開いてくれた酵母遺伝学トレーニングコースの集合写真。酵母の扱い方を一から学ぶことができただけではなく、酵母研究者とのつながりを作ることができた。大島研の助手の東江昭夫さん(現・東大名誉教授:2列目左端)と原島俊さん(現・阪大名誉教授:後列右端)、受講生の堀内嵩さん(現・基生研名誉教授:前列左から2番目)らがいる。(本人:後列右から2番目)
ロイポルド先生60歳の誕生日を記念した国際会議では、世界中の分裂酵母の研究者が、先生の営むスイスの牧場を訪れた。(右側がロイポルド夫妻)

牧場の朝焼け。
同会議で、みんなからロイポルド先生へアルペンホルンをプレゼント。研究者同士がとても仲が良かったことも、分裂酵母を続けようと思う決め手になった。
ポール・ナース博士(右から2番目)と。ポールは僕たちが開発した技術をうまく取り入れて細胞周期の制御因子を突き止め、ノーベル賞を受賞した。(本人:右端)
分裂酵母をモデル生物に
自分で少し分裂酵母を触ってみた後に、柳田さんに「分裂酵母を材料にしましょう」と進言しました。柳田さんは細胞の形態観察を専門にしていましたから、分裂酵母の細胞分裂の仕方が気に入ったようです。科学的な根拠があったわけではないのですが、分裂酵母は独特の増え方をする出芽酵母と違ってきれいに二分裂して増えるので、私たち多細胞動物により近いのではないかという直観がありました。実際ゲノム研究が進むにつれ、出芽酵母にはない分裂酵母と私たちの共通点が具体的に見えてきました。分裂酵母は数億年も前に出芽酵母から分化した生物であり、例えば出芽酵母の遺伝子にはイントロンがほとんどないのに、分裂酵母の遺伝子には存在しています。またタンパク質のアミノ酸配列を比べると、出芽酵母よりも分裂酵母のほうが、よりヒトに似ていることも分かったのです。直観的に選んだのですが、非常にラッキーでしたね。
新しい実験設備を整えるため、京大に着任した年はあちこち奔走しました。酵母のコロニーを新しいシャーレに移し替える際、毛足の短いベルベット生地にコロニーをくっつけるので、その生地を四条の呉服屋へ買いに行くことから始めました。「毛足が短いのは『ベッチン』いう低級品や。うちにはないよ」と何件も断られ、やっと見つけた記憶があります。そういった苦労もしながら、一つ一つ設備を整えていきました。
1981年に東大に移り、小さいながら独立した研究室を持つことになってからは、いよいよ減数分裂の問題に的を絞ろうと考えていました。とはいえ減数分裂は僕自身の目標であり、大きな流れとしては真核生物で日本発の新しい宿主・ベクター系を確立することが求められていたので、まずそこに集中することにしました。特定の遺伝子をプラスミドプラスミド染色体外DNAの一つで、宿主染色体と独立して自律増殖する、寄生性の遺伝因子。組換えDNA技術においてベクターとして広く用いられる。などのベクターベクター組換えDNA技術において、目的の遺伝子を細胞内へ導入・増殖させるための外来DNAのこと。につないで分裂酵母の細胞に導入し、その遺伝子のはたらきを調べられる系の開発です。分裂酵母を大腸菌や出芽酵母に次ぐ「認定宿主・ベクター系」認定宿主・ベクター系特殊な培養条件下以外での生存率が低い宿主と、当該宿主以外の生物への伝達性が低いベクターとを組み合わせた系のうち、文部科学大臣が定めるもの。にするという計画で、恩師の内田先生や深沢先生、東大の飯野徹雄先生たちが科研費の研究班に入れてくれたのは助かりましたね。僕たちは、マーカーとなる遺伝子に分裂酵母の複製開始点を結合させて、自律複製するプラスミドを作り上げました。このプラスミドに標的の遺伝子を結合させて分裂酵母に導入し、そのはたらきを調べる実験系を作るのです。ところがポール・ナースらが、出芽酵母が元来持っている「2ミクロンDNA」というプラスミドを分裂酵母に導入して自律複製をさせるという、驚きの方法で実験系を作り上げ、『Nature』に発表してしまいました。先を越されてしまったのは少し残念でしたが、僕たちが開発した方法は後に、ポール・ナースがヒトのcdc遺伝子を分裂酵母に入れて機能させる際に使いました。彼はこの研究でノーベル賞を獲りましたから、僕らがやったことが無駄にならず、お互い補い合うことができたのは幸いでした。

京大時代、講演のため来日したジェームズ・ワトソン(左から3番目)を歓迎するために餅つき大会を開催。餅をついているのは平岡泰さん(現・大阪大学教授)。(本人:右から2番目、柳田氏:左から2番目)
東大講師の頃の研究室メンバーと。最初の大学院生の飯野雄一君(後列左)、二期生の渡邊嘉典君(後列右)らとMei2の解析を始めていた。(本人:左端 )
東大の遺伝子解析施設で開いた酵母実験のトレーニングコースでの集合写真。日本の酵母研究の源流となるメンバーが集まった。
遺伝子実験のルール作りの取りまとめ役だった深沢俊夫さん(前列左から5番目)、後に植物研究へ進む田畑哲之さん(現・かずさDNA研究所所長:前列左から2番目)、オートファジー研究の大隅良典さん(後列右から3番目)、酵母脂質代謝研究の太田明德さん(現・中部大学副学長:後列右から4番目)らと。(本人:後列左から2番目)
減数分裂の第一歩
酵母を使うことの一番の利点は、養分の少ない環境に移すだけで減数分裂を開始させられることです。また、減数分裂ができない突然変異体を得るのが簡単なことも挙げられます。例えばショウジョウバエなどは減数分裂でしか子孫を残せませんから、減数分裂ができない突然変異体の子孫はすぐに絶えてしまいます。これでは材料として維持することができません。でも酵母は、栄養さえあれば体細胞分裂と同じように無性的に増えることができます。だから減数分裂ができない系統の株も簡単に維持できるのです。
東大に移って初めて来てくれた学生は2人でした。うち一人の中西伸樹くん(現・シンチロン研究所主任研究員)は先ほど言った宿主・ベクター系の開発を行い、もう一人の飯野雄一くん(現・東大教授)は減数分裂に関係する突然変異体をスクリーニングする作業を始めました。こうして取れたのが、減数分裂の抑制に関わるpat1という遺伝子の突然変異体で、高温に移すと抑制が外れて減数分裂を開始するという面白い表現型を示します。うちの研究室がその後長い間続けてきた仕事の出発点です。名前の由来は、英語の「単為生殖:parthenogenesis」から名づけました。実はちょうどそのころ、イギリスのポール・ナースとデビッド・ビーチらのグループも全く同じ遺伝子の突然変異体を取ってran1と名づけていました。名前の由来は、温度が上がるとすぐ子どもができることから「身持ちの悪い:randy」。英語を母国語とする彼らならではの、ユーモア含みの命名です。
僕たちはもう一つ、mei2という極めて重要な遺伝子を発見しており、Mei2タンパク質とPat1タンパク質が共同で、減数分裂の開始を支配していると見ていました。ところがデビッド・ビーチたちもやはりmei2の突然変異体に到達していたのです。彼は「競争を避けるために、どっちがどっちをやるか決めよう」という交渉のために日本にやってきました。mei2の解析は、大阪市大の下田親さん(現・大阪市大特任教授)と共同研究で進めていたこともあり、結局pat1(彼らの言うran1)を譲り、僕たちはmei2に集中することになりました。
まず、大学院生の渡邊嘉典くん(現・東大教授)がmei2の塩基配列を明らかにすることに専念しました。ところが、分かった塩基配列を当時のデータベースに登録された他の遺伝子の塩基配列と比べたところ全く相同性がなく、Mei2タンパク質がどんな機能を持っているのかさっぱり分かりません。一方のデビッド・ビーチらはpat1の塩基配列を解読し、それがプロテインキナーゼの遺伝子であることを早々に解明して『Nature』に発表してしまいました。プロテインキナーゼは、リン酸化という作用によってタンパク質の活性を変化させるはたらきをもちます。つまりPat1は何らかの因子を不活性化させることで、通常は細胞が減数分裂に入らないように抑制しているようなのです。それならばMei2がその不活性化の標的なのではないか。そう考えて実験したところ、予想通りMei2タンパク質の構造の中に2か所、Pat1キナーゼでリン酸化される場所があることが分かりました。渡邊くんの発見です。Pat1が機能しなくなるとリン酸基が外れてMei2が活性化し、減数分裂が始まることが分かったのです。証明にだいぶ時間がかかってしまいましたが、僕たちの手中にあるMei2こそが、減数分裂の開始の鍵を握る制御因子であることが確実となりました。
Mei2がつくるスポットの謎
Mei2が、どのようにして減数分裂の開始を制御しているのかを追究するのが次のステップです。実はMei2に関しては、もう一つ面白いことが分かってきました。データベースが充実してくるとともに、その塩基配列には3か所のRNA結合部分がありそうだという話になったのです。ちょうどMei2と機能的に関連するsme2という遺伝子が、どうやらタンパク質としてではなくRNAとして機能するのではないかと疑われていたときで、Mei2はこのsme2のRNAと結合する可能性があると考えました。当時、遺伝子はmRNAを介してタンパク質として翻訳されて、始めて機能を発揮するのだという考え方が主流でした。だからsme2のように翻訳されない状態、すなわちRNAの状態ではたらく遺伝子はほとんど知られていませんでした。減数分裂に必要なRNAなどあるのか、実は僕たちも半信半疑でしたが、調べてみるとMei2は確かにsme2のRNAと直接結合しますし、sme2の遺伝子を壊すと減数分裂は第一分裂の前で止まってしまいます。Mei2がsme2のRNAに結合することが、減数分裂の開始に必要だということは決定的でした。
この結果を『Cell』に投稿したところ、創刊者で編集長のベンジャミン・レヴィンから直接手紙が来ました。彼も驚いたのでしょう。その内容は、「非常に面白い結果だが、sme2がごく小さなタンパク質として翻訳された状態ではたらいている可能性がないわけではない。RNAとしてはたらいていることを確実に示すために、追加の実験をして欲しい」というもので、急いで実験を行なってデータを送りました。そのころはまだFAXでのやり取りしかなく、時差があるので夜中に研究室に詰めて返事を待ったものです。トランスファーRNAやリボソームRNA以外で、RNAとしてはたらく遺伝子の存在を示した研究例としては非常に早い時期のものでしたね。
次のステップとして、RNAと結合したMei2が細胞のどこにいるのかを蛍光染色で見てみました。柳田さんの研究室の学生だった、通信総合研究所の平岡泰さん(現・阪大教授)らとの共同研究です。すると減数分裂の際には、Mei2が核内の一点に集まって小さなスポットを作っていることがわかりました(図1)。調べていくと、それは染色体上のsme2遺伝子のごく近くでした。sme2遺伝子が転写されてRNAが出てくると、そこにMei2が集まってきて結合し、その場に留まると考えられます。Mei2は常にsme2のRNAを目印にして集まるらしく、sme2遺伝子の位置を染色体上で動かしてみると、どこにあってもそこに集まってきてスポットをつくります。転写されたRNAのもとに特定の因子が集まるという興味深いことが分かったのですが、なぜ集まってスポットを作るのか、それが減数分裂の制御とどう関係しているのかという究極的な疑問は、長い間謎のままでした。
(図1)減数分裂期の核内でつくられるMei2スポット
Mei2タンパク質は減数分裂期に入ると、染色体上にあるsme2遺伝子の近くに集まる。
メッセンジャーはなぜ消えるのか
スポットの謎は解けぬままでしたが、研究室では減数分裂の際にはたらいていると見られる他の多くの遺伝子についても解析を進めていきました。減数分裂に関係していそうな遺伝子を細胞内ではたらかせて、出てくる効果からその機能を調べようと考えたのです。ところがそういった遺伝子の中には、栄養増殖している細胞でいくら人為的にはたらかせようとしても、細胞の中に翻訳されたタンパク質が出てこないものがあったのです。最初は学生の実験が下手なためだろうと思っていました。ところが、遺伝子は転写されているはずなのに、その産物であるmRNAすら見当たらないことが分かってきました。しかも不思議なことに、減数分裂の最中の細胞ではこれらの遺伝子がちゃんと転写・翻訳されてはたらくのです。減数分裂していないときの細胞の中では、何かがこれらの遺伝子の邪魔をしている。また新しい謎が出てきました。
実はこれは、mmi1という遺伝子の仕業だと分かりました。Mmi1タンパク質はRNAに結合する性質を持ち、減数分裂に関わる遺伝子から転写されてきたmRNAに結合してRNAを分解する複合体・エキソソームへと導き、壊してしまうのです。しかし全てのmRNAがMmi1に壊されてしまうわけではなく、壊されるのは減数分裂に関わる特定の遺伝子のmRNAだけ。Mmi1が何らかの配列を認識し、それを持つmRNAだけを壊しているようなのです。一体何を識別しているのか? 色々な遺伝子のmRNAが標的になっていることは確かでしたが、それらの共通点がなかなか分かりませんでした。しかしある時、学生の一人が「壊されるmRNAの一部には、5~6塩基の繰り返しがよく出てくるようだ」と気付きました。標的となるmRNAは、その1,000〜2,000塩基のRNA配列の一部に、たった6塩基のモチーフが何度も繰り返し現れる領域を持っていました。驚いたことにMei2スポットの足場となるsme2のRNAも、その配列を大量に持つものの一つだったのです。
こうして分かってきたのは、減数分裂の際にはたらく遺伝子は普段からある程度転写されているということです。普段は、それらの転写産物であるmRNAをMmi1が絶えず見つけて壊すので、減数分裂は起こりません。テレビの画面を切っていても主電源を入れておくのと同じ理屈で、無駄は承知で減数分裂に関わるmRNAを普段から少しずつ出しておき、栄養状況が変わったときにパッと減数分裂に移れるよう準備しているようなのです。
2000年の研究室の集合写真。学生には一人一テーマが原則。誰かの手伝いをする形での研究を指示したことはない。
ノーベル賞受賞後に来日したポール・ナース夫妻と渡邊君と。渡邊君(右端)は研究室の助手時代にポール・ナースのもとに2年間留学した。(本人:左端)
減数分裂の分子が出会う「場」
遺伝子のmRNAを壊すというMmi1のはたらきが、思いがけず長年謎のままだったMei2のスポットの意味に結びつきました。実はMmi1は、減数分裂が始まるとある一点に集まっていくのですが、驚いたことにそれはまさに、Mei2が集まるスポットの場所だったのです。Mei2とsme2のRNAがつくるスポットがMmi1を引きつけ、スポットに留めてそのはたらきを押さえ込んでしまうのです。こうして、それまでMmi1に抑制されていた遺伝子群が一斉にはたらきはじめ、速やかに減数分裂が始まるのです。何とも見事ですよね。Mmi1とMei2の出会いが、減数分裂のスイッチなのです。これが分かった時は興奮しましたね。並行して行なっていた二つの研究がつながり、減数分裂に関わる分子が一斉に動き出す過程が見えたのですから。
大学院生の張ケ谷有里子さん(現・コロラド大学研究員)が中心となって、Mmi1のはたらきと、それがMei2のスポットに結びついて減数分裂の開始を制御するという一連の過程をまとめて『Nature』に投稿しました。編集部が論文を2つの短報に分けて出すよう言ってきたのですが、あくまで1つの論文として出すことにこだわりました。減数分裂の抑制から開始までの過程を、1つながりの物語として世に出したかったのです。
減数分裂は真核生物に広く引き継がれている現象であるにも関わらず、その分子機構は生きものによって個性があるようです。実は僕たちが分裂酵母で少しずつ明らかにしていった減数分裂の機構は、その一つに過ぎません。減数分裂でDNAの組み換えを起こす酵素は、生物間で比較的保存されていることが分かっていますが、その前の段階、つまり僕たちが明らかにした減数分裂開始のスイッチの部分の分子機構がどこまで生物間で共通なのかは、全く手付かずの領域なのです。
人間は大きな自然の一部であり、自然の全てを知りたがること自体、とてつもなく僭越なことなのかもしれません。けれど僕たちが知りたがり屋に生まれついているのもまた自然の成せる業です。生きものの起源は一つですから、どうしてこれだけ多様で複雑な生命現象があるのか、いつか説明がつく日が来るだろうという希望を持って進んでいます。

(図2)減数分裂に関わる遺伝子は、特定の6塩基の配列をもっている。
減数分裂をしていない細胞でこれらの遺伝子が転写されると、6塩基の配列を 識別したMmi1が転写産物(mRNA)を分解するため、減数分裂は起こらない。
減数分裂が開始される細胞では、Mei2とsme2 RNAがMmi1のはたらきを抑えこむので、 減数分裂に関わる遺伝子のmRNAが分解されず、安定的にはたらける。
自然の一部としての生きものに向き合う
学生は一人、一テーマという形で研究できるようにするのが、指導教員としての僕の方針です。一つのテーマに向き合い、きちんと考えて研究すれば、修士の2年間だけでも1つは面白いことが出てきますし、博士までいけば2つか3つは面白いことを見つけられるものです。若い人には、「先生に言われたからやらなければ」と思うのではなく「このテーマについて世界一よく知っているのは自分だ」という自負を持って欲しい。僕の研究室では本当にたくさんの人が、自分自身のテーマで研究に取り組んできました。例えば初期の大学院生の渡邊くんは、減数分裂の際の染色体分配に興味を持ち、後に「シュゴシン」という因子を発見しました。相同な染色体がくっついて分かれる「還元分裂」がどのように制御されるのか。この非常に面白い問題に、彼独自のアイデアで迫っています。
僕らが子どものころ、ノーベル賞を受賞した湯川秀樹先生はほとんど神様のような存在でした。けれど最近ではいろいろな分野・経歴の日本人がノーベル賞を受賞しているでしょう。自然体でやっていれば誰でもいい仕事ができる時代になってきているのは、本当に良いことだと思いますね。一方で、日本のノーベル賞受賞者の研究成果の多くは20〜30年前に育ったものであり、今に目を向けると若い研究者はポストがなくて困っている状態です。若い人が希望を持てなくなってしまったら、それこそ科学にとっては命取りです。組織を代表する立場になった今は自分の欲をなるべく抑えて、科学研究の在り方を考えていかなくてはならないと思っています。
最近の学術研究費に関する議論では、「研究分野の選択と集中を推し進めれば、もっと効率的にお金が使えるに違いない」という意見が必ず出てきます。しかし、どこに行き着くか分からない問題に長年取り組んできた僕の経験からすると、決してそうはいきません。一見調べても無駄だと思うような現象も、後になってみると財産だったと分かるのが常です。そういった遊びを許容できる環境がないと、自然科学は前に進みません。人間はある所まで来たらすぐ分かった気になってしまうものですが、たいていの場合は浅知恵ですよ。自然は常に僕たちより一枚も二枚も上手で、ここまでやってくれるかという驚きに満ちています。手強い自然に向き合い本当に面白いテーマを見つけるには、本気で没頭し、考え続ける人が必要です。もちろん研究の知見は皆のためになるように用いるべきですから、研究を応用して経済の発展につなげていくことの必要性も分かります。しかし、これは勝手な言い分かもしれませんが、全人類の0.01パーセントぐらいは純粋に基礎研究が大好きな人がいるでしょう。そういう人たちの在り方を認めて、研究に没頭できる場を与えて欲しいですね。科学を前進させるのは、不思議を探し、絶えず考え続ける研究者一人ひとりの意志以外にないのですから。

久しぶりに会いに行った野村先生ご夫妻。カリフォルニアのご自宅近くで撮影。大腸菌から酵母の研究に移った野村先生とは、留学以来ずっとお付き合いが続いた。
今年、シュゴシンを発見した渡邊嘉典くんと共同で朝日賞を受賞。写真に収まりきらないほどの数の関係者や教え子が集まってくれた。(本人と渡邊氏:前列中央紅白の胸章)
妻とともに、5年に1回行なわれるワルシャワのショパンコンクールに行くのが最近の趣味。若いピアニストたちによる、思いの込もった演奏を楽しみにしている。
現在の「所長研究室」のメンバー。研究室の運営はほぼ全て准教授の山下朗さん(右から2番目)に任せて、自分は研究所長としての仕事に専念している。(本人:中央)

























